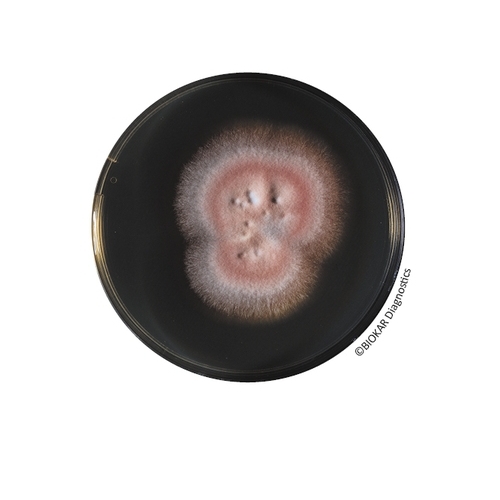
Sabouraud Dextrose Agar (SDA)

Sabouraud Dextrose Agar (SDA)
Sabouraud Dextrose Agar is a classical medium for the culture, isolation and identification of yeasts & molds in sterility tests of pharmaceutical and cosmetic products. It is also used in the specific detection of Candida albicans in pharmaceutical products.
| Ürün Adı | Sabouraud Dextrose Agar (SDA) |
| Ürün Kodu | BM05308 |
| Miktar | 10 vials of 200 mL |
| Ürün Adı | Sabouraud Dextrose Agar (SDA) |
| Ürün Kodu | BK025HA |
| Miktar | 500 g |
| Ürün Adı | Sabouraud Dextrose Agar (SDA) |
| Ürün Kodu | BM17308 |
| Miktar | 20 Petri plates Ø 90 mm |